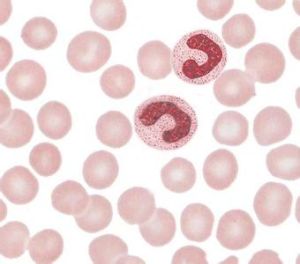
桿狀型

桿狀型
渦蟲表皮(epidermis)由外胚層來的柱形上皮細胞組成,其中有桿狀體(rhabdites),當渦蟲遇刺激時桿狀體排出體外,彌散有毒性的黏液,供捕食和防禦敵害之用。
渦蟲表皮(epidermis)由外胚層來的柱形上皮細胞組成,其中有桿狀體(rhabdites),當渦蟲遇刺激時桿狀體排出體外,彌散有毒性的黏液,供捕食和防禦敵害之用。
渦蟲表皮(epidermis)由外胚層來的柱形上皮細胞組成,其中有桿狀體(rhabdites),當渦蟲遇刺激時桿狀體排出體外,彌散有毒性的黏液,供捕食和防禦敵害之用。
桿狀骨針是海綿體動物的骨片(也稱骨針),因形狀似桿狀而得名。海綿動物除了個別的科沒有骨骼之外,其他所有的種類都是具有骨骼的,骨骼是海綿動物的一個典型特徵...
海綿動物的骨針 從形態上區分的骨針中性桿狀核粒細胞是外周血中中性粒細胞的分葉情況為桿狀的中性粒細胞。桿狀核與分葉核之間的正常比值為1:13,又稱為核左移。常見於感染,尤其是化膿菌引起的急...
正常值 臨床意義 注意事項 檢查過程 相關症狀桿狀DNA病毒屬,病毒是中等免疫原性,一些病毒之間有血清學關係。該屬大多數種的病毒粒子存在於寄主植物的所以組織中,病毒只分布在細胞質中,單個或成群不規則...
代表種 病毒特性 理化特徵 核酸 蛋白質成人型慢性粒細胞白血病(adultchronic myelogenous leukemia,ACML)發病年齡在5歲以上,以10~14歲較多見,很少見於...
流行病學 病因 發病機制 臨床表現 診斷革蘭陽性菌細胞壁缺失後, 原生質僅被一層細胞膜包住,稱為原生質體(protoplast);革蘭陰性菌肽聚糖層受損後尚有外膜保護,稱為原生質球(spher...
細菌L型 由來 分布 形成 生物特性此型幾乎皆發生在5歲以下兒童,尤以2歲以下的嬰幼兒多見。男性發病多於女性。可發生於家族性神經纖維瘤,生殖泌尿系畸形或智力低下的患兒。起病可急或緩,常以呼...
流行病學 病因 發病機制 臨床表現 診斷桿狀體肌病( NM)為一種少見的先天性肌病,此病屬非進行性先天性肌病,女性發病率高於男性。患兒呈軟嬰兒,均伴有肌張力低下;肌無力症狀上肢重於下肢。該病按...
簡介 類型 病因 病理水轟-5飛機的外形很美,修長的機身兼船身保證了水面漂浮時具有良好的縱向穩定性。 飛機可連續飛行11小時55分鐘或4906千米。 水轟-5飛機先在水庫水面...
簡介 尺寸數據